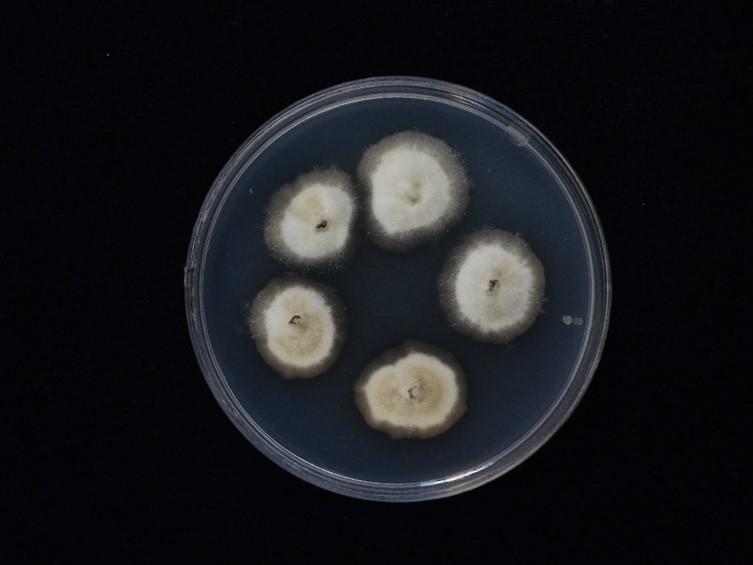

Holotype:
THAILAND, Khon Kaen Province, Phu Wiang National Park, 18 Jul. 2017, K. Tasanathai, S. Mongkolsamrit, W. Noisripoom, B. Sakolrak, W. Himaman, P. Jangsantear, holotype BBH 47785, ex-type living culture BCC 85351.
Habitat:
Underside of leaves.
Host:
Lepidoptera larva.
Description:
 Stromata several, cylindrical, branched mostly erect, 50-100 mm long, 1 to 2 mm wide, yellow to brown, with a sterile tip, on larvae of Lepidoptera in the leaf litter.
Stromata several, cylindrical, branched mostly erect, 50-100 mm long, 1 to 2 mm wide, yellow to brown, with a sterile tip, on larvae of Lepidoptera in the leaf litter.  Perithecia superficial, densely packed covering lower part to apex of stroma, ordinal in arrangement, subglobose to ovoid, 290-390 × 240-300 μm.
Perithecia superficial, densely packed covering lower part to apex of stroma, ordinal in arrangement, subglobose to ovoid, 290-390 × 240-300 μm.  Asci hyaline cylindrical, 8-spores, 135-210 × 5-7.5 μm. Ascospores filiform, 145-187.5 × 2-2.5 μm, remain whole after discharge, with septation.
Asci hyaline cylindrical, 8-spores, 135-210 × 5-7.5 μm. Ascospores filiform, 145-187.5 × 2-2.5 μm, remain whole after discharge, with septation.
Culture characteristics:
Colonies on PDA attaining a diam of 10 mm in 20 d at 20 °C, light brown, reverse brown, myceliumsmooth-walled. Conidiogenous cells phialidic, swollen at the base or slightly flask-shaped, with tiny warts, 29–40 × 3 μm, helical twising at the apex of phialide neck. Conidia hyaline, smooth, ellipsoid or lemon-shaped, arising from the apex of the neck singly, 5–8 × 3–5 μm, surrounded by mucous sheath.
Colonies on PDA attaining a diam of 10 mm in 20 d at 20 °C, light brown, reverse brown, myceliumsmooth-walled. Conidiogenous cells phialidic, swollen at the base or slightly flask-shaped, with tiny warts, 29–40 × 3 μm, helical twising at the apex of phialide neck. Conidia hyaline, smooth, ellipsoid or lemon-shaped, arising from the apex of the neck singly, 5–8 × 3–5 μm, surrounded by mucous sheath.
Reference:
Tasanathai K, Thanakitpipattana D, Himaman W, et al. (2020). Three new Ophiocordyceps species in the Ophiocordyceps pseudoacicularis species complex on Lepidoptera larvae in Southeast Asia. Mycological Progress 19: 1043–1056.
DOI: https://doi.org/10.1007/s11557-020-01611-6Species |
Strain |
Compound |
Pubchem CID |
Biological activity |
Reference |
|---|
|
Strain |
LSU | RPB1 | RPB2 | TEF1 |
|---|---|---|---|---|
| BCC 85351 | - | MT118187 | MT118195 | MT118174 |
| BCC 86207 | MT118179 | MT118184 | MT118192 | MT118171 |
| BCC 86208 | MT118180 | MT118185 | MT118193 | MT118172 |